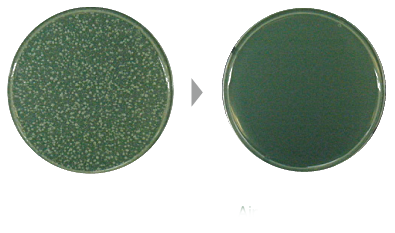

Is it a patented technology?
A patent application has been filed for non-woven inkjet output material (application number: 10-2020-007160) with deodorant and antibacterial functions.
Is there a test report on deodorization and Antibacterial?
It is certified by the internationally accredited testing institution FITIResearch Institute for its odor removal performance and is recognized for its dysfunction against four major types of harmful bacteria, including Staphylococcus Aureus.
Do you have a certificate?
Approved for the material safety of life chemical products by the Korean Construction and Life Environment Institute (KCL).
Is a report certificate issued?
A certificate of conformity report from the Korea National Environmental Technology Institute has been issued. A certificate of conformity was issued.
What is Airpurity's price competitiveness?
There are almost no commercial products to compare, but it is 4-8 times more economical than antibacterial stickers. Compared to other products, it is overwhelmingly competitive by field standards.
Deodorization and antibacterial activity, deodorization, antimicrobial treatment capacity per hour, sustainability, application volume, application area etc.
Is the sales price always constant?
As the number of people infected with virus continues, the prices of products such as masks and hand sanitizers are rising, but this product will always be offered at the same price.
How long does the odor removal ability last?
The duration of the odor removal ability is about 6 to 12 months, but it depends on the type and concentration of the odor there.
Can microorganisms (bacteria) be removed?
It can remove 99.9% of 4 kinds of pathogens. (Four pathogens Escherichia coli, Salmonella bacteria, Klebsiella pneumoniae, Yellow grape billiard bacteria)
How much bacteria are destroyed when I touch with my hands?
With one touch, it disappears 50-70%. However, the transfer rate of the antimicrobial touch surface varies depending on the amount of bacteria in the palm of the individual and the pressure at which the antimicrobial touch is applied.
What is the antibacterial function field?
Antibacterial touch products have antibacterial properties on the entire surface, so only the area in contact with the palm is sterilized.
What is the expiration date of the antibacterial touch?
In general, use from 1000 times to a maximum of 3000 times. However, the antibacterial property is preserved even if it is used more than 1000 times, but it is recommended to replace it every 6 months as bacterial contamination and contact pressure vary depending on the installation site.
Are there any harmful substances?
The RoHS test determined that there are no hazardous substances. RoHS (restriction of the use of certain Hazardous Substances in electrical and electronic equipment) is a regulation for the use of certain hazardous substances and six specific hazardous substances (lead (Pb)) in environmental regulations brought by the European Union (EU). This system restricts the use of cadmium (Cd), mercury (Hg), hexavalent chromium (Cr6 +), PBBs (polybromated diphenyl ethers) and PBDEs (polybromated diphenyl ethers).
What is the purpose of the antibacterial touch?
Manage general and personal hygiene with antibacterial function.
It is installed in places and places such as offices, factories, buildings, supermarkets, restaurants, department stores, duty free shops, airports, railways, subways, buses, taxis, etc.
Laptops, mobile phones, desks, personal items, etc. that require personal hygiene. Use for.
Can we verify the persistence of antibacterial function by ourselves?
Special measuring equipment is required (ATP tester equipment). Antibacterial touch surface can be controlled.
How should the unused products be stored?
It is recommended to be stored in a sealed packaging to prevent air contact after opening.
Usually, a house can be stored in a zippered bag. However, the life of the product after opening depends on storage conditions.
Is it possible to return?
Deodorant/antibacterial function starts immediately after opening, so it is impossible to return the product.